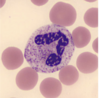

RESPIRATORY EPITHELIUM
pseudostratified columnar epithelium
w/ goblet cells
will transition to simple cuboidal in bronchioles,
then to simple squamous in alveolar ducts and alveoli!
(i.e. Type I cells, fn of gas exchange)
note: the parts which come into contact w/ external envt
(e.g. part of pharynx and larynx)
= STRATIFIED SQUAMOUS epithelium
Main mucles involved in respiration
Diaphragm and chest wall muscles
- Inspiration: CONTRACT
to move down and move ribs down
=> increase intrathoracic volume - Expiration: RELAX
to allow thoracic cavity to recoil
=> decrease intrathoracic volume
thus,
inspiration = ACTIVE process
expiration = PASSIVE process
which is/are true about intrapleural pressure?
A) Intrapleural pressure is always greater than intrapulmonary pressure
B) Intrapleural pressure is always less than intrapulmonary pressure
C) Intrapleural pressure is always greater than atmospheric pressure
D) Intrapleural pressure is always less than atmospheric pressure
B) and D)
- Intrapleural < Intrapulmonary
in order to keep lungs expanded
- Intrapleural < Atmospheric
as lungs have tendency to collapse inward due to elastic recoil while chest wall has natural tendency to expand outward
-> negative pressure acts like vacuum
=> prevents lung from collapsing
relationship bet intrapulmonary pressure and atmospheric pressure during inspiration
intrapulmonary pressure < atmospheric pressure
-> pressure gradient drives air to flow INTO lungs
relationship bet intrapulmonary pressure and atmospheric pressure during expiration
intrapulmonary pressure > atmospheric pressure
-> pressure gradient drives air to flow OUT of lungs
causes of change in intrapleural pressure
increased air or fluid in pleural space
increased air = pneumothorax
increased fluid = pleural effusion (serous fluid) OR haemothorax (blood)
which sensors (and where) detect changes in O2
Peripheral chemoreceptors
in aortic and carotid bodies
senses mainly O2, but also CO2 and pH
which sensors (and where) detect changes in CO2
Central chemoreceptors
in medulla
senses mainly CO2 and pH
which drive is normally a more potent stimulator of ventilation,
hypoxic (low pO2) or hypercapnic (high pCO2)?
hypercapnic
bcos normal range of pCO2 is 35-45mmHg
and hypercapnic drive has range of 45-70mmHg
=> more sensitive
normal range of pO2 is 80-100mmHg
and hypoxic drive has range of less than 60mmHg
=> less sensitive
since chemoreceptors of pCO2 is in medulla (brain),
most powerful respiratory stimulant in healthy person is
decreased CSF pH
In what scenario will patients rely more on hypoxic drive for ventilation
COPD patients
bcos there is chronic CO2 retention
-> blood becomes chronically more acidic
-> blood buffers step in to normalise blood pH
=> less stimulation of chemoreceptors even though CO2 remains high
implications:
giving oxygen supplementation
-> reduce hypoxic drive
=> cause decreased ventilation instead of increased ventilation
definition of tidal volume (TV)
volume of air entering or exiting lungs
with EACH passive breath

definition of inspiratory reserve volume (IRV)
extra air entering lungs with maximum inspiration

definition of expiratory reserve volume (ERV)
extra air exiting lungs with maximum expiration

definition of vital capacity (VC)
total volume of air which can be moved in or out of lungs
(i.e. TV + IRV + ERV)

Which of the following is true about Functional Residual Capacity (FRC)?
A) It is the total amount of air in the lungs after normal exhalation.
B) It consists of Expiratory Reserve Volume (ERV) and Residual Volume (RV).
C) It plays a key role in preventing large fluctuations in alveolar gas composition.
D) All of the above.
D) All of the above.
FRC = ERV + RV,
and represents the volume of air left in the lungs AFTER a normal expiration

helps maintain steady oxygen and CO₂ levels.
air flow in, air flow out or both
Compliance vs Elasticity vs Airway resistance
in relationship to airflow
- Compliance
= stretchability
=> affects how easily air flows IN - Elasticity
= recoil
=> affects how easily air flows OUT - Airway resistance
= resistance to airflow
=> affects how easily air flows IN AND OUT
what is compliance affected by
- surfactant
which disperses the fluid molecules on lining of alveoli
-> decreases surface tension
=> thus helping alveoli stretch - fibrosis
- skeletal deformities
1 pathology linked to surfactant production is neonatal respiratory distress syndrome
where insufficient surfactant production
-> alveoli collapse,
esp in not fully developed lungs of premature neonates
what is airway resistance affected by
- size of airway
(changes with bronchoconstriction and bronchodilation) - mucus accumulation
pathologies linked to this are
* asthma: bronchoconstriction + mucus overproduction
(and also airway swelling/oedema)
* drugs (anti-adrenergics, anti-cholinergics, anti-inflammatory): bronchodilation or bronchoconstriction
difference in pressure and flow in lungs
compare bet before birth/fetus vs after birth/adults
- before birth: high pressure, low flow
due to lungs being prevented from being used for gas exchange
-> constriction of pulmonary blood vessels
-> high resistance in these blood vessels
=> high pressure, low flow - after birth: low pressure, high flow
due to lungs having function of gas exchange
-> dilation of pulmonary blood vessels
-> low resistance in these blood vessels
=> low pressure, high flow
before birth,
oxygenation occurs via placenta
and blood from RV bypasses lungs via ductus arteriosus and foramen ovale
what does restrictive lung disease affect
- limit lung expansion
=> reduced compliance - since lungs now resist expansion more
=> high recoil
what does obstructive lung disease affect
- impede airflow
=> increased airway resistance
how does restrictive lung disease affect FEV1/FVC ratio
increase in FEV1/FVC
(to ≥ 0.7-0.8)
* due to air having difficulty ENTERING lungs
lung volumes are reduced (FVC decrease)
=> less air available to be exhaled in 1st second of forced exhalation too (FEV1 decrease)
* however due to high recoil
-> rapid expiration in 1s
=> FEV1 decreases less than FVC
how does obstructive lung disease affect FEV1/FVC ratio
decrease in FEV1/FVC
(to ≤ 0.7-0.8)
due to airway impedement
-> exhalation (passive process) being limited and thus slowing down
=> decreased FEV1
also have decrease in FVC
as patient cannot exhale completely
-> air being trapped
however, decrease in FEV1 > decrease in FEV1
Why is oxygen (O₂) more affected than carbon dioxide (CO₂) in many respiratory pathologies?
A) O₂ has a higher solubility in blood than CO₂
B) CO₂ has a greater solubility in blood than O₂
C) O₂ is actively transported across the alveolar membrane
D) CO₂ is not affected by ventilation-perfusion mismatches
B) CO₂ has a greater solubility in blood than O₂
thus CO2 is more efficiently removed than O2 is taken up
-> O2 levels are affected first in various pathologies
=> ventilation must be severely impaired before CO2 retention (hypercapnia) occurs